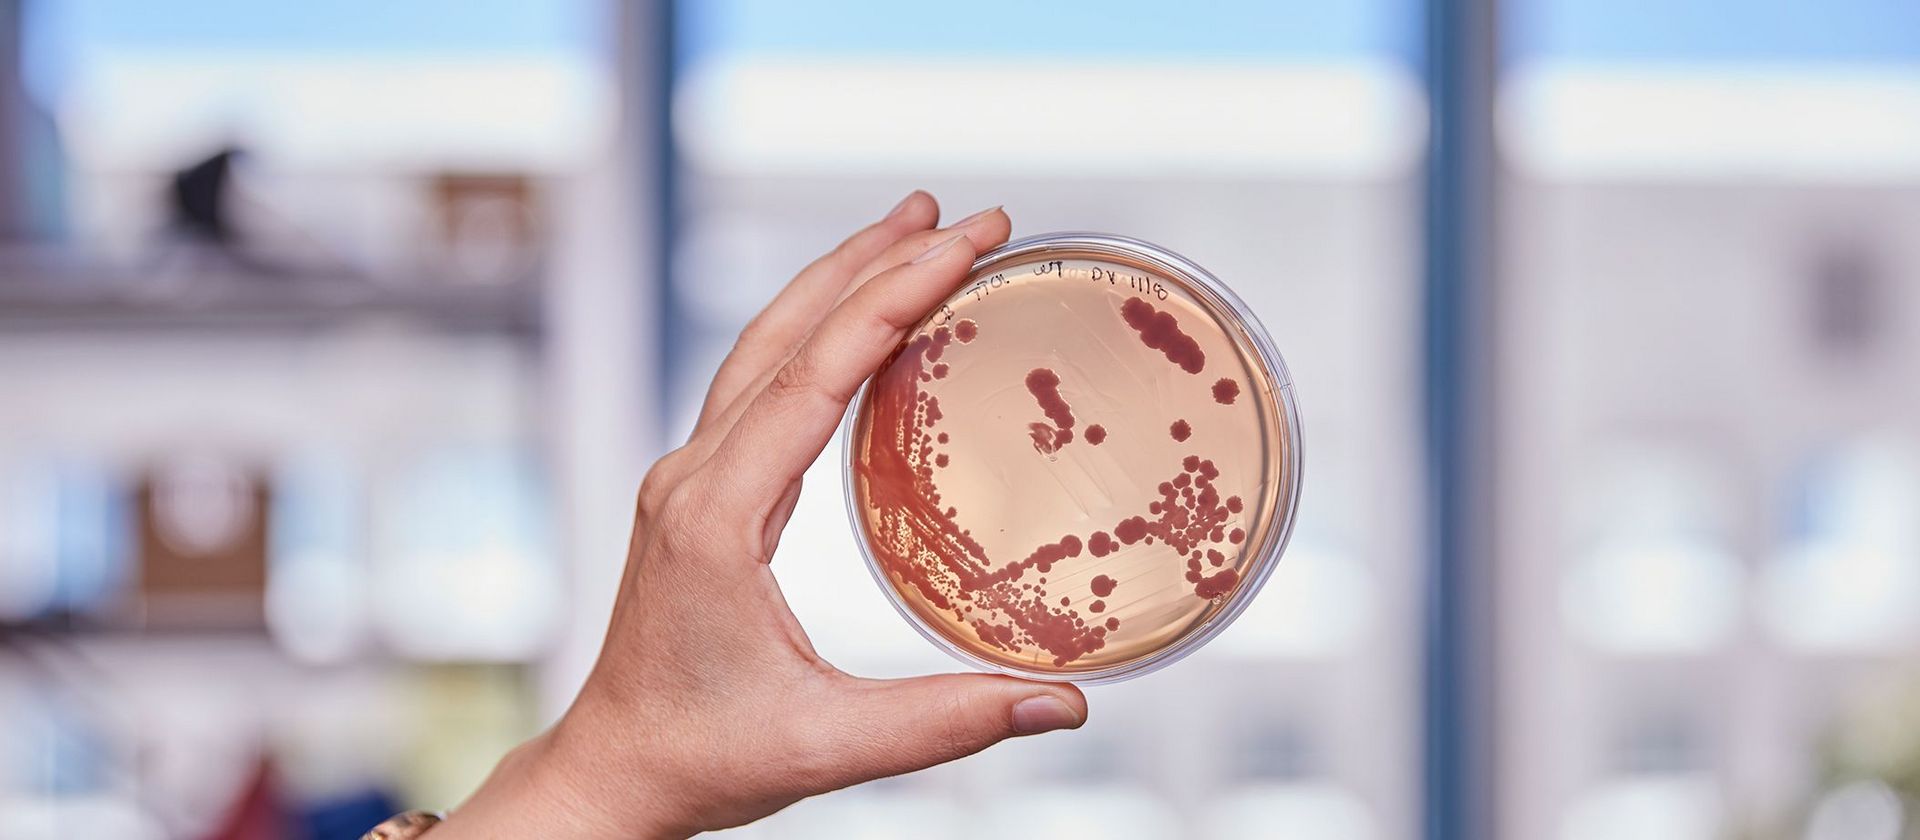

Saarbrücken, 22. März 2024 – Viele wichtige Medikamente, wie Antibiotika und Krebsmedikamente, sind von Naturstoffen aus Bakterien abgeleitet. Die Enzymkomplexe, die diese Wirkstoffe produzieren, gelten aufgrund ihres Baukastenprinzips als ideales Werkzeug für die Synthetische Biologie. Durch Erforschung der Protein-Evolution fand ein Team um Prof. Helge Bode vom Max-Planck-Institut für Terrestrische Mikrobiologie, darunter Dr. Kenan Bozhüyük, der jetzt eine Nachwuchsgruppe am Helmholtz-Institut für Pharmazeutische Forschung Saarland (HIPS) leitet, neue „Fusionsstellen“, die eine schnellere und gezieltere Wirkstoffentwicklung ermöglichen.
Industrielle Produktion folgt meist dem Fließbandprinzip: Bauteile werden systematisch zu komplexen Produkten zusammengesetzt, wobei verschiedene Fertigungsstraßen unterschiedliche Produkte ergeben. Doch die eigentlichen Erfinder dieses Prinzips sind nicht Menschen, sondern Bakterien. die Nicht-ribosomale Peptid-Synthetasen (NRPS) sind bakterielle Enzyme, die, ähnlich wie Fertigungsstraßen, eine immense Vielfalt an Naturstoffen hervorbringen. Dadurch können sich die Bakterien in der Natur in den unterschiedlichsten Lebensräumen behaupten. Wir Menschen verdanken den riesigen Enzymkomplexen viele wichtige Medikamente, wie Antibiotika.
Die große Auswahl an Produkten entsteht dabei weniger durch die Menge an Bausteinen, sondern durch die Vielfalt der NRPS selbst, die sich aus der Kombination ihrer Enzym-Untereinheiten ergibt. Jede NRPS-Variante kann jeweils andere Bausteine binden, aktivieren und miteinander verknüpfen.
Das Team um Prof. Helge Bode am Max-Planck-Institut für terrestrische Mikrobiologie in Marburg forscht daran, dieses Enzymsystem für die gezielte Wirkstoffproduktion im Labor zu nutzen. Die Forschenden verändern Teile der Enzyme und damit die funktionellen Eigenschaften ganzer Enzymkomplexe (NRPS-Engineering), sodass sie Produkte mit neuen Eigenschaften bilden.
Doch obwohl dieser Ansatz bereits seit einigen Jahren verfolgt wird, funktionierte er bisher noch nicht wie erhofft. „Wir denken, dass eine große Chance darin liegt, die Natur zum Vorbild zu nehmen. Wenn wir die natürlichen Prozesse verstehen, wissen wir, welche Bereiche im Enzym am besten für das NRPS-Engineering geeignet sind“, sagt Dr. Kenan Bozhüyük, einer der Erstautoren der Studie, die im Fachmagazin Science erschien. Kenan Bozhüyük ist mittlerweile Nachwuchsgruppenleiter für „Synthetische Biologie von mikrobiellen Naturstoffen“ am Helmholtz-Institut für Pharmazeutische Forschung Saarland (HIPS). Das HIPS ist ein Standort des Helmholtz-Zentrums für Infektionsforschung (HZI) in Braunschweig in Zusammenarbeit mit der Universität des Saarlandes.
Um herauszufinden, welche Untereinheiten des Enzyms besonders gut miteinander zusammenarbeiten, konzentrierte sich das Team auf die Frage, an welchen Positionen die Evolution ansetzt, um neue „Fließbänder“ zusammenzubauen oder zu verändern, damit benötigte Wirkstoffe entstehen. Zusammen mit der Gruppe von Dr. Georg Hochberg (ebenfalls MPI) und Prof. Michael Groll (TU München) suchte das Team nach Hotspots der natürlichen Rekombination. „Dazu haben wir mehrere zehntausend Enzyme bioinformatisch analysiert und die Analyse anschließend mit Laborexperimenten kombiniert, um die vorhergesagten Zielstellen zu überprüfen“, erklären die Erstautoren Leonard Präve und Dr. Carsten Kegler.
Tatsächlich fand das Team einen neuen Fusionspunkt für die gezielte Herstellung funktionsfähiger NRPS-Hybride. Mit seiner Hilfe konnten schließlich sogar NRPS-Sequenzen aus völlig unterschiedlichen Organismen wie Bakterien und Pilzen miteinander kombiniert werden. Ihr neues Wissen überprüften die Forschenden dann in einem medizinischen Zusammenhang: Sie konstruierten ein neues, pharmakologisch aktives Peptid. Die breit angelegte Studie zeigt das große Potenzial der bakteriellen Naturstoffe als Grundlage neuer Medikamente.
„Im Bereich der synthetischen Biologie und der evolutionären Biochemie hat die Forschung in den letzten Jahren enorme Fortschritte gemacht,“ sagt Helge Bode, Direktor am Max-Planck-Institut in Marburg. „Der Vorteil unseres Ansatzes ist, dass wir evolutionäre Prozesse nutzen, die sich über Millionen von Jahren bewährt haben. Unsere von der Evolution inspirierten Fusionsstellen sind vielseitiger und haben höhere Erfolgsraten.“
In ihrem Ansatz kombinieren die Forschenden die synthetische Biologie mit Hochdurchsatzmethoden, die für das schnellere und damit kostengünstigere Auffinden biologisch aktiver Wirkstoffe notwendig sind. Damit wollen die Forschenden zukünftig maßgeschneiderte biologische Arzneimittel mit verbesserten therapeutischen Eigenschaften entwickeln – was angesichts der Zunahme an Arzneimittel-Resistenzen und Wirkstoff-Unverträglichkeiten immer wichtiger wird.
Pressemitteilung des Max-Planck-Instituts für Terrestrische Mikrobiologie
Originalpublikation:
Kenan Bozhüyük, Leonard Präve, Carsten Kegler, et al. Evolution-inspired engineering of nonribosomal peptide synthetases. Science (2024). DOI: 10.1126/science.adg4320

![[Translate to German:] Alexandra K. Kiemer, Simon Both, Martin Empting](/fileadmin/HIPS/__processed__/c/6/csm_Kiemer_Both_Empting_7700535100.jpg)

















![[Translate to English:] Illustration](/fileadmin/HIPS/__processed__/b/6/csm_WebNews_DataLeakage_53fd0ef4a5.png)

































![[Translate to German:] [Translate to German:]](/fileadmin/HIPS/__processed__/c/9/csm_HZI_wiss_hemmhof_mik_001_611abc3df4.jpg)




![[Translate to German:] [Translate to German:]](/fileadmin/HIPS/__processed__/1/b/csm_Andreas_Keller_2023_org_029c5088c1.jpg)

![[Translate to German:] [Translate to German:]](/fileadmin/HIPS/__processed__/b/3/csm_AufDiePlaetze_WID-8615_4ee837e55b.jpg)

![[Translate to German:] Künstliche Intelligenz unterstützt die Entdeckung von Arzneimitteln aus Naturstoffen](/fileadmin/HIOH/News/AI_in_NP_Drug_Discovery_AdobeStock.jpg)
































![[Translate to Deutsch:] [Translate to Deutsch:]](/fileadmin/HIPS/__processed__/2/b/csm_HZI_wiss_pseudomonas_cpi_hzi_001_62730ae12d.jpg)

















